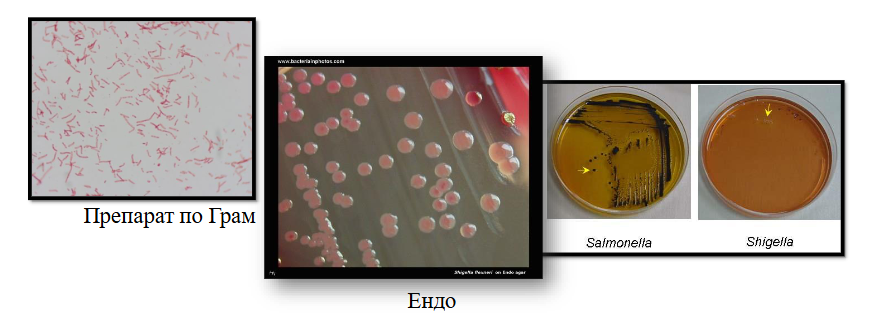
<ul><li><p><span><span>Посявка при леглото на болния</span></span></p></li><li><p><span><span>Културелно изследване – ОА, диференциращи ХС – Ендо, Левин,<br>селективни – АЦА, SS-агар</span></span></p></li><li><p><span><span>Биохимична и серологична</span></span><br><span><span>идентификация на изолираната чиста</span></span><br><span><span>култура (аглутинация тип Грубер)</span></span></p></li></ul><p></p>

1/8
Looks like no tags are added yet.
Name | Mastery | Learn | Test | Matching | Spaced | Call with Kai |
|---|
No analytics yet
Send a link to your students to track their progress
Какво е шигелоза(дизентерия)?
остри инфекциозни заболявания, характеризиращи се с ентероколитен синдром и патологични изменения в дисталния отдел на дебелото черво
Кои са представителите на род Shigella?
S. dysinteriae
S. flexneri
S. boydii
S. sonnei
Какво е характерно за род Shigella?
от сем. Enterobacteriaceae
грам-отрицателни пръчици
не образуват капсули
не образуват спори
нямат ресни→неподвижни(разлика със самонелите)
факултативни анаероби
невзискателни

Антигенна структура:
соматични О-антигени
Дизентерия:
предава се чрез заразени храни, води и мухи
фекално-орален
механизъм на заразяване
инкубационният период е средно 3-5 дни
инфекцията е самоограничаваща се
продължава 6-10
Клинична картина на дизентерия:
колит, диария, тенезми (непродуктивни
болезнени напъни за дефекация)
обща слабост
главоболие
висока температура
в изпражненията има слуз и кръв

Клинични материали:
фецес
Лабораторна диагностика:
Посявка при леглото на болния
Културелно изследване – ОА, диференциращи ХС – Ендо, Левин,
селективни – АЦА, SS-агар
Биохимична и серологична
идентификация на изолираната чиста
култура (аглутинация тип Грубер)
Лечение и профилактика:
Има изработени ваксини, които индуцират имунитет само няколко
месеца
За лечение – ампицилин, TMP/SMZ